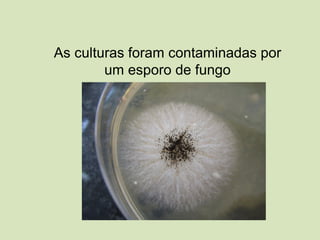
As culturas foram contaminadas por
um esporo de fungo
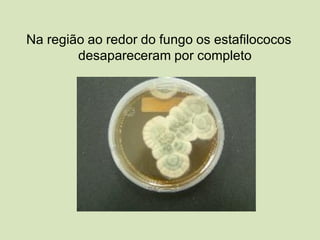
Na região ao redor do fungo os estafilococos
desapareceram por completo

O documento discute o que é ciência e pensamento científico. Ele define ciência como a busca do conhecimento desde os tempos antigos até a era moderna, com o objetivo de compreender a realidade. Explora os tipos de conhecimento, caracterizando o conhecimento científico como aquele que pode ser testado através de evidências e é passível de revisão. Também discute a metodologia científica, incluindo a formulação de hipóteses e experimentos para testá-las.